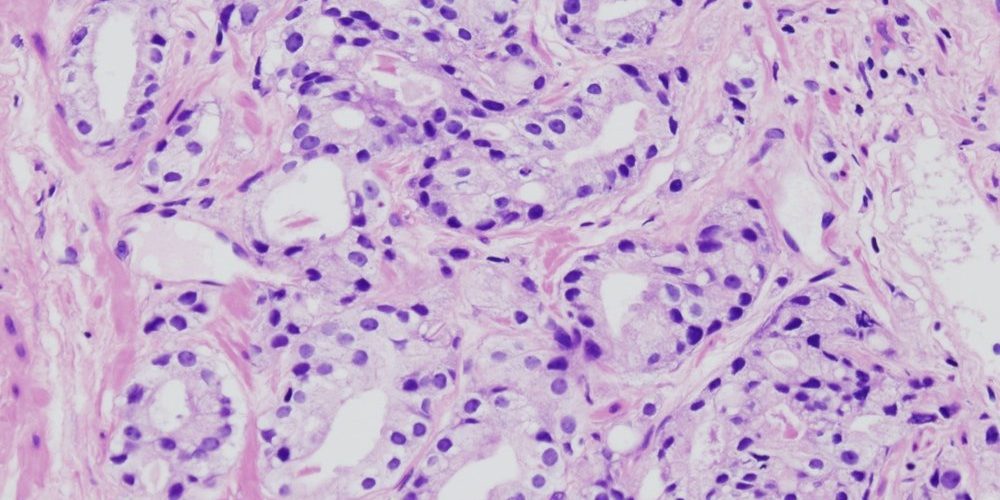

Ученые нашли причину агрессивности рака простаты

Исследователи из Онкологического центра Джонса Хопкинса Киммела определили белок, регулирующий липиды, который наделяет клетки рака простаты устойчивостью, провоцирует агрессивное их распространение. Результаты исследования представлены в журнале Molecular Cancer Research.
В экспериментах на клеточной линии человека, удаление CAVIN1 из стромальных клеток заблокировало использование липидов ими. Однако липиды присутствовали в окружающей среде, став для клеток рака своего рода шведским столом. Они использовались для стимулирования роста, укрепления защитной мембраны вокруг клетки, синтеза белков и выработки тестостерона для поддержки роста рака.
Исследователи говорят, что потеря CAVIN1 в опухолевых клетках потенциально может быть использована в качестве биомаркера риска метастазирования.
материал med2.ru